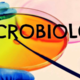
Microbiologia

-
 El descubrimiento de los microorganismos tuvo que esperar hasta la invención del microscopio . El microscopio fue inventado por Zacharias Janssen en 1590.
El descubrimiento de los microorganismos tuvo que esperar hasta la invención del microscopio . El microscopio fue inventado por Zacharias Janssen en 1590. -
El matemático y naturalista inglés Robert Hooke (1635-1703) fue un excelente microscopista. Hooke ilustró, entre otras muchas cosas, los cuerpos fructificantes de los mohos. Fue la primera descripción conocida de un microorganismo.
-
 El primero que observó las bacterias, las células microbianas más pequeñas, fue Antoni van Leeuwenhoek (1632-1723), un holandés vendedor de telas y aficionado a la microscopía. Van Leeuwenhoek construía microscopios muy simples con una sola lente para examinar diversas sustancias naturales en busca de microorganismos. Las descubrió en 1676 mientras estudiaba infusiones de pimienta. La historia de la biología lo considera precursor de la biología celular y de la microbiología.
El primero que observó las bacterias, las células microbianas más pequeñas, fue Antoni van Leeuwenhoek (1632-1723), un holandés vendedor de telas y aficionado a la microscopía. Van Leeuwenhoek construía microscopios muy simples con una sola lente para examinar diversas sustancias naturales en busca de microorganismos. Las descubrió en 1676 mientras estudiaba infusiones de pimienta. La historia de la biología lo considera precursor de la biología celular y de la microbiología. -
Uno de los principales causantes de ello fue Ferdinand Cohn ,científico germano .Su interés por la microscopía le llevó a estudiar las algas unicelulares y, más tarde, las bacterias.Cohn estaba especialmente interesado en la resistencia de las bacterias al calor, y su investigación le condujo al descubrimiento de la formación de endosporas por parte de algunas bacterias.Demostró que las células vegetativas morían al someterlas a ebullición, pero no las endosporas, que eran resistentes.
-
 El químico francés Louis Pasteur (1822-1895) era un químico de formación y fue uno de los primeros en reconocer la importancia de los isómeros ópticos. Mediante sus experimentos descubrio la primera separación de enantiómeros. Los enantiomeros son isómeros ópticos de una sustancia química que resultan imágenes especulares entre sí.
El químico francés Louis Pasteur (1822-1895) era un químico de formación y fue uno de los primeros en reconocer la importancia de los isómeros ópticos. Mediante sus experimentos descubrio la primera separación de enantiómeros. Los enantiomeros son isómeros ópticos de una sustancia química que resultan imágenes especulares entre sí. -
 Esta teoría ha existido desde los tiempos bíblicos y explica que si se deja durante algún tiempo comida o algún otro material perecedero a la intemperie se pudre. Pasteur se opuso a la generación espontánea. A partir de sus descubrimientos y experimentos , Pasteur predijo que los microorganismos de la materia putrefacta procedían de células que habían llegado por el aire o de células que habían estado en el material en descomposición desde el principio.
Esta teoría ha existido desde los tiempos bíblicos y explica que si se deja durante algún tiempo comida o algún otro material perecedero a la intemperie se pudre. Pasteur se opuso a la generación espontánea. A partir de sus descubrimientos y experimentos , Pasteur predijo que los microorganismos de la materia putrefacta procedían de células que habían llegado por el aire o de células que habían estado en el material en descomposición desde el principio. -
 Louis Pasteur empezó a estudiar el mecanismo de la fermentación alcohólica. La observación al microscopio y otros experimentos convencieron a Pasteur de que la fermentación alcohólica estaba catalizada por microorganismos vivos, las células de levadura. A partir de estos estudios fundacionales, Pasteur empezó una serie de experimentos clásicos sobre la generación espontánea, experimentos que quedarán ligados para siempre a su nombre y a la ciencia de la microbiología.
Louis Pasteur empezó a estudiar el mecanismo de la fermentación alcohólica. La observación al microscopio y otros experimentos convencieron a Pasteur de que la fermentación alcohólica estaba catalizada por microorganismos vivos, las células de levadura. A partir de estos estudios fundacionales, Pasteur empezó una serie de experimentos clásicos sobre la generación espontánea, experimentos que quedarán ligados para siempre a su nombre y a la ciencia de la microbiología. -
 Mediante técnicas de microscopía estableció que las bacterias estaban presentes en la sangre de los animales que sucumbían a la enfermedad. Sin embargo, Koch argumentaba que la asociación de la bacteria con la enfermedad no era una demostración de relación causa-efecto y aprovechó la oportunidad de estudiar experimentalmente esta relación usando carbunco en animales de laboratorio. Los resultados de esta investigación sentaron las bases del estudio de las enfermedades infecciosas desde entonces.
Mediante técnicas de microscopía estableció que las bacterias estaban presentes en la sangre de los animales que sucumbían a la enfermedad. Sin embargo, Koch argumentaba que la asociación de la bacteria con la enfermedad no era una demostración de relación causa-efecto y aprovechó la oportunidad de estudiar experimentalmente esta relación usando carbunco en animales de laboratorio. Los resultados de esta investigación sentaron las bases del estudio de las enfermedades infecciosas desde entonces. -
El trabajo de Pasteur sobre la rabia fue su mayor éxito, y culminó en julio de 1885 con la administración de la primera vacuna contra la rabia a un ser humano, un joven francés llamado Joseph Meister a quien había mordido un perro rabioso.
-
 El naturalista, botánico, y microbiólogo neerlandés Martinus Beijerinck (1851-1931) hizo dos grandes contribuciones a la microbiología: el descubrimiento de los virus y el desarrollo de técnicas de cultivo microbiológico.
El naturalista, botánico, y microbiólogo neerlandés Martinus Beijerinck (1851-1931) hizo dos grandes contribuciones a la microbiología: el descubrimiento de los virus y el desarrollo de técnicas de cultivo microbiológico. -
 Thomas Brock (nacido el 10 de septiembre de 1926) es un microbiólogo estadounidense conocido por su descubrimiento de hipertermófilos que viven en aguas termales en el Parque Nacional Yellowstone en el año 1967. Brock afirmó que las bacterias son capaces de crecer a cualquier temperatura en la que exista agua líquida, incluso en estanques que estén por encima del punto de ebullición. Desde entonces se han descubierto más de 70 especies.
Thomas Brock (nacido el 10 de septiembre de 1926) es un microbiólogo estadounidense conocido por su descubrimiento de hipertermófilos que viven en aguas termales en el Parque Nacional Yellowstone en el año 1967. Brock afirmó que las bacterias son capaces de crecer a cualquier temperatura en la que exista agua líquida, incluso en estanques que estén por encima del punto de ebullición. Desde entonces se han descubierto más de 70 especies.
A list shows items. A timeline shows sequence.
Use Timetoast to make dates, milestones, and turning points easier to understand in a clear visual format. Timetoast is a timeline maker for work, school, research, and stories.